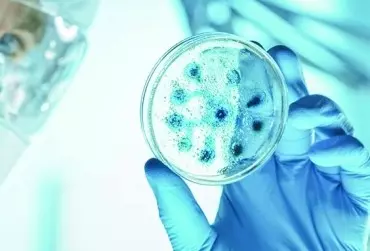

Madagaskar, zwany Czerwoną Wyspą, położony jest w pobliżu południowo-wschodniej części Afryki nad Oceanem Indyjskim. Wyspa o powierzchni 587 tys. km2 może poszczycić się wyjątkowym bogactwem roślin i zwierząt.
Dział: Otwarty dostęp
Proszę tylko spojrzeć na uczniów w swojej klasie. Ilu z nich ma zaokrąglone kształty? Czy to coś nadzwyczajnego? Kto z nas nie zna powiedzenia „Motylem byłem, ale utyłem”, które niestety odnosi się również do najmłodszych. Według ekspertów z Instytutu Żywności i Żywienia w latach 70. poprzedniego wieku mniej niż 10% uczniów, podczas gdy obecnie już co piąte dziecko w wieku szkolnym boryka się z nadwagą lub otyłością dziecięcą
Qwady są najliczniejszą grupą stawonogów, której przedstawiciele występują niemal we wszystkich ekosystemach lądowych i wodnych. Siedliska nieposiadające swojej entomofauny to tylko rowy oceaniczne oraz głębie mórz i oceanów. Pod względem różnorodności, liczby gatunków, liczebności osobników oraz rozprzestrzenienia owady osiągnęły najwiękzy sukces ewolucyjny wśród wszystkich zwierząt na naszej planecie. A ponieważ te małe, często niezauważane istoty charakteryzują się nadzwyczajnymi zdolnościami adaptacyjnymi, niewykluczone, że w końcu zapanują na Ziemi. Na lądzie owady są szeroko rozpowszechnione i występują niemal we wszystkich biotopach: można je spotkać od biegunów, na obu strefach podbiegunowych, po równik. Owady roją się na pustyniach, w lasach, pływają w wodzie, drążą korytarze głęboko w glebie, żyją w ciemnościach głębokich mrocznych jaskiń i latają ponad szczytami Himalajów. Mimo że są one głównie formami lądowymi, niektóre przystosowały się do życia w wodach słodkich, pewne gatunki żyją w gorących słonych źródłach wulkanicznych, a nawet w kałużach ropy naftowej wypływającej z ziemi.
Wirusy to groźne mikroskopijne cząsteczki zakaźne, które od milionów lat występują na całej planecie i mogą zakażać wszystkie formy życia (zwierzęta, rośliny, grzyby i bakterie). Co ciekawe, nie są uważane za organizmy ze względu na brak budowy organellowej i maszynerii molekularnej niezbędnej do replikacji i produkcji własnych białek. Przetrwanie zapewnia wirusom pasożytniczy tryb życia i wykorzystywanie molekularnych systemów w komórkach zainfekowanego gospodarza.